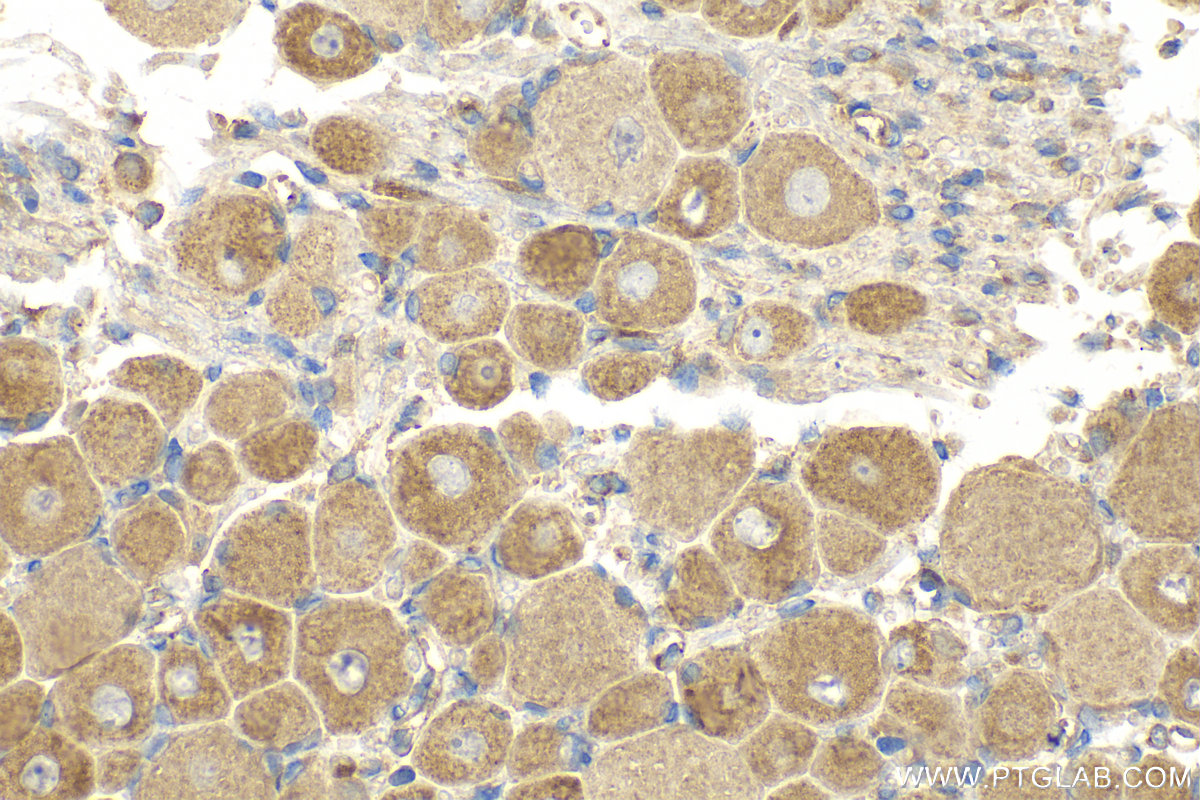

验证数据展示
经过测试的应用
| Positive WB detected in | SH-SY5Y cells, SK-N-SH cells, pig colon tissue |
| Positive IHC detected in | mouse cerebellum tissue, mouse brain tissue, rat dorsal root ganglion tissue Note: suggested antigen retrieval with TE buffer pH 9.0; (*) Alternatively, antigen retrieval may be performed with citrate buffer pH 6.0 |
推荐稀释比
| 应用 | 推荐稀释比 |
|---|---|
| Western Blot (WB) | WB : 1:1000-1:4000 |
| Immunohistochemistry (IHC) | IHC : 1:250-1:1000 |
| It is recommended that this reagent should be titrated in each testing system to obtain optimal results. | |
| Sample-dependent, Check data in validation data gallery. | |
产品信息
19124-1-AP targets TRPA1 in WB, IHC, IF, ELISA applications and shows reactivity with human, mouse, rat, pig samples.
| 经测试应用 | WB, IHC, ELISA Application Description |
| 文献引用应用 | WB, IHC, IF |
| 经测试反应性 | human, mouse, rat, pig |
| 文献引用反应性 | human, mouse, rat |
| 免疫原 |
Peptide 种属同源性预测 |
| 宿主/亚型 | Rabbit / IgG |
| 抗体类别 | Polyclonal |
| 产品类型 | Antibody |
| 全称 | transient receptor potential cation channel, subfamily A, member 1 |
| 别名 | ANKTM1, p120, Wasabi receptor |
| 计算分子量 | 140 kDa |
| 观测分子量 | 120-130 kDa |
| GenBank蛋白编号 | NM_007332 |
| 基因名称 | TRPA1 |
| Gene ID (NCBI) | 8989 |
| RRID | AB_10642143 |
| 偶联类型 | Unconjugated |
| 形式 | Liquid |
| 纯化方式 | Antigen affinity purification |
| UNIPROT ID | O75762 |
| 储存缓冲液 | PBS with 0.02% sodium azide and 50% glycerol, pH 7.3. |
| 储存条件 | Store at -20°C. Stable for one year after shipment. Aliquoting is unnecessary for -20oC storage. |
背景介绍
TRPA1, also named as ANKTM1, belongs to the transient receptor family. TRPA1 is a receptor-activated non-selective cation channel involved in detection of pain and possibly also in cold perception and inner ear function. TRPA1 has a central role in the pain response to endogenous inflammatory mediators and to a diverse array of volatile irritants, such as mustard oil, garlic and acrolein, an irritant from tears gas and vehicule exhaust fumes. It acts also as a ionotropic cannabinoid receptor by being activated by delta(9)-tetrahydrocannabinol (THC), the psychoactive component of marijuana. It may be a component for the mechanosensitive transduction channel of hair cells in inner ear, thereby participating in the perception of sounds.
实验方案
| Product Specific Protocols | |
|---|---|
| IHC protocol for TRPA1 antibody 19124-1-AP | Download protocol |
| WB protocol for TRPA1 antibody 19124-1-AP | Download protocol |
| Standard Protocols | |
|---|---|
| Click here to view our Standard Protocols |
发表文章
| Species | Application | Title |
|---|---|---|
Metabolism IFT80 and TRPA1 cooperatively regulate bone formation by calcium signaling in response to mechanical stimuli | ||
Phytomedicine Yu-Xue-Bi capsule ameliorates aggressive synovitis and joint damage in rheumatoid arthritis via modulating the SUCNR1/HIF-1α/TRPV1 axis | ||
J Control Release A dual receptors-targeting and size-switchable "cluster bomb" co-loading chemotherapeutic and transient receptor potential ankyrin 1 (TRPA-1) inhibitor for treatment of triple negative breast cancer. | ||
Front Pharmacol The efficacy of ophiopogonanone B in treating the cough in mice infected with Mycoplasma pneumoniae | ||
J Ethnopharmacol Ligustilide covalently binds to Cys703 in the pre-S1 helix of TRPA1, blocking the opening of channel and relieving pain in rats with acute soft tissue injury | ||
Mol Nutr Food Res Menthol from Mentha piperita Suppresses the Milk Production of Lactating Mammary Epithelial Cells In Vivo and In Vitro. |